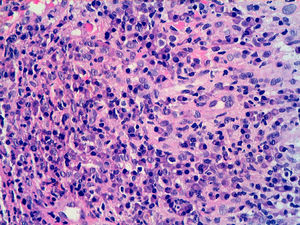
Detalle del infiltrado linfoplasmocitario, con vasos de endotelio prominente (H-E x200).

Describimos el caso de un paciente de 25 años de edad, de nacionalidad rumana, sin antecedentes médico-quirúrgicos de interés, que consultó por la presencia de una lesión ulcerada asintomática en el tórax, de aproximadamente 4 semanas de evolución. No presentaba fiebre ni otra sintomatología sistémica asociada. No tenía historia de enfermedad de transmisión sexual en el pasado y refería ser heterosexual, sin pareja estable.
En la exploración física se apreció una lesión ovalada erosionada en la cara anterior del tórax, de consistencia dura a la palpación, de unos 30 x 20mm de diámetro, con un fondo mamelonado, fuertemente eritematoso, con aspecto de tejido de granulación, y un borde sobreelevado de coloración más rosada, muy bien delimitado (fig. 1). La lesión era asintomática también a la palpación. En el resto del tronco se observaron unas lesiones lineales acompañantes, distribuidas de forma dispersa y aleatoria, que el paciente no consideraba relevantes, aunque se negó a facilitarnos la naturaleza de las mismas. En la región axilar derecha se demostró una adenopatía indurada no dolorosa de pequeño tamaño.
Se solicitaron cultivos para hongos y bacterias que fueron negativos. Se realizó una biopsia cutánea en la que se objetivó la presencia de un intenso infiltrado plasmocitario en la dermis superficial y profunda, de carácter policlonal con técnicas de inmunohistoquímica (figs. 2 y 3).
En la analítica se confirmó el diagnóstico de sífilis con la presencia de RPR 1/4, y TPHA positivo 1/320. El resto de la serología solicitada, incluyendo el VHB, VHC y VIH fue negativa.
La úlcera mejoró drásticamente con penicilina oral, que se instauró el día de la consulta inicial, con resolución total de la lesión. Con el diagnóstico de sífilis primaria se administró posteriormente una dosis de penicilina G benzatina intramuscular (2.400.000 U).
La sífilis es una enfermedad infecciosa sistémica causada por la espiroqueta Treponema pallidum. La transmisión de la enfermedad se realiza por el contacto con lesiones infectivas, que generalmente se localizan en la región anogenital.
Los chancros extragenitales son infrecuentes, encontrándose en un 5-14% de los casos, y pueden aparecer en cualquier parte de la superficie corporal1. Se sitúan con mayor frecuencia en los labios, la región perioral y la cavidad oral, en relación con el sexo oral sin protección. Se han descrito localizaciones menos comunes como la barbilla, el oído, el cuello, los brazos2,3 e incluso en el pezón tras la mordedura por un paciente sifilítico4,5. La afectación de los dedos se ha publicado escasamente, y se atribuye a la contaminación por microtraumas, típico en algunas profesiones como en ginecólogos, matronas, cirujanos y/ o dentistas6. Se presenta como un panadizo doloroso, con esclerosis difusa, alrededor de las uñas.
Recientemente Lautenschlager ha publicado un caso similar al descrito en este artículo en un paciente con un chancro primario localizado en el tronco, con una adenopatía axilar no dolorosa1. Este autor solo encuentra casos similares registrados en textos antiguos de Dermatología, y cita 21 casos de chancros extragenitales localizados en el tronco publicados por Alfred Fournier, de un total de 642 casos, lo cual representa un 3% de los mismos7. Posiblemente las erosiones lineales que presentaba el paciente, y que sugerían arañazos desde el punto de vista clínico, favorecieran la penetración de la espiroqueta a través del tejido y su multiplicación posterior.
Las características morfológicas de los chancros localizados tanto en la región genital como extragenital son similares. Sin embargo, las lesiones ulceradas localizadas en la región extragenital requieren un alto índice de sospecha clínica.
La confirmación debe realizarse con la serología mediante las pruebas treponémicas y no treponémicas y el estudio histopatológico. No hay que olvidar que la lesión primaria puede estar presente de una a tres semanas antes de que las serologías sean positivas. En este caso el diagnóstico requiere la demostración de la presencia del Treponema pallidum en el exudado de la lesión. La reacción en cadena de la polimerasa (PCR) se presenta como un método de diagnóstico muy útil en estos casos, aunque no está disponible de forma rutinaria en todos los hospitales. La técnica de inmunohistoquímica con anticuerpos específicos para la detección del Treponema pallidum ofrece unos resultados positivos en sífilis primaria y secundaria, en torno al 80%.
En el diagnóstico diferencial deben incluirse otras causas infecciosas de úlceras cutáneas, como Mycobacterium, herpes simple, donovanosis, tularemia, leismaniasis o esporotricosis6. A veces es necesario excluir procesos tumorales, primarios o metastáticos y granulomatosos1.
Debido a la alta infectividad y a la morbilidad asociada, la sífilis primaria sigue siendo un importante problema de salud pública. Cualquier ulceración indolora asociada con una linfadenopatía regional, también asintomática, debería hacernos sospechar el diagnóstico de sífilis primaria.
Este trabajo recibió el premio al mejor trabajo sobre ETS presentado en el 38 Congreso Nacional de Dermatología y Venereología celebrado en Málaga en mayo del 2010.